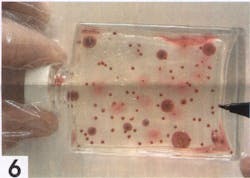
Microbmonitor2 10139347 Microbmonitor2 10139347

MicrobMonitor2
IATA approved MicrobMonitor2 is easy to use. This kit allows you to test the water or fuel phase of aviation fuel. The test consists of a bottle containing a thixotropic nutrient gel that promotes the growth of bacteria and yeast/molds. Once a sample has been added to the bottle, the container is placed in a warm, dark place for 72 hours. The microbes actually grow in and on the gel. They will show up as red or purplish red dots in the sample bottle indicating a positive result. If you require a quantitative number there is a color chart to compare the results against. Generally, any positive growth requires action and biocide treatment. The benefit in using the MicrobMonitor2 kit over the LiquiCult Test Kit is that the MicrobMonitor2 uses a syringe without a needle, making it safer for the operator to use. Visit www.fqsinc.com or call 800-827-9790 / 770-967-9790.